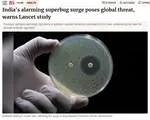
vb0peb5mv5.png

Recent Posts
How often do you get haircut
Blaady
RGTOW general #1
This is why you should never trust white girls
cananadian tourist in India
yaar gobarjeeta
Amriki Report on China
BROATUL
BLT bros...
Arattai Thread
Androidbros, idhar aa
Pahadi aesthetics
Single men above 30 should pay extra taxes which s...
We got Will smith 2.0 Before GTA 6
long covid
Androidbros, idhar aa

i5nGPc
No.347826
Steam started adding android games

WWrGtg
No.347828
>>347826(OP)
Ha toh kya kare?

mtoIHO
No.347839
>>347826(OP)
fuck yeah. I hope the google play store dies

oA4vDl
No.347844
>>347826(OP)
Based but how does it affect sideloading issues created by google?

oHhB5G
No.347858
>>347844
sideloading is here to stay